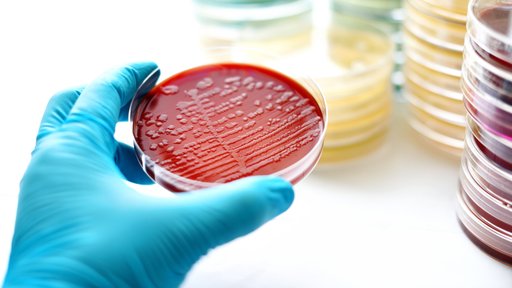

Mikrobiologie – Einführung in die Welt der Mikroorganismen, Teil 1/3
-
Teilnahmebescheinigung
Die Ausstellung dieser Bescheinigung setzt die vollständige Teilnahme an dem Online-Seminar voraus. Die Bescheinigung kann nur für den registrierten Teilnehmer ausgestellt werden.
-
Handout
Der Abruf von Handouts setzt die vollständige Teilnahme an dem Online-Seminar voraus.
Unsere Haut, ein Wunderwerk der Natur, ist besiedelt mit Mikroorganismen. Unsere Hautflora stellt eine einzigartige Zusammenstellung von Mikroorganismen bereit, die mit uns in Koexistenz leben – sie sind Teil unseres Immunsystems.
Im ersten Teil dieser Reihe möchten wir Ihnen die verschiedenen Formen und Varianten von Mikroorganismen näherbringen und ihre einzigartigen Eigenschaften erkunden, bevor wir uns dann der Frage widmen, warum Mikroorganismen manchmal krank machen und manchmal nicht. Zudem wollen wir wichtige Begriffe wie aerob, anaerob, intermediär oder resistent übersetzen und ihre Bedeutung in Bezug auf Wunden verstehen.
Berufsgruppe
MFA
Zielsetzung
Nach diesem Online-Seminar …
- verstehen Sie die Besonderheiten von Mikroorganismen.
- verstehen Sie die Grundbegriffe der Mikrobiologie.
- kennen Sie die Zusammensetzung der Hautflora und verstehen deren Besonderheit.
Inhalte
- Mikroorganismen
- Nähere Betrachtung ausgewählter Mikroorganismen
- Grundbegriffe der Mikrobiologie
- Hautflora
- Quiz
Dauer
45 Minuten
Zertifikat
Die Ausstellung eines Zertifikates setzt die vollständige Teilnahme an dem Online-Seminar voraus. Das Zertifikat kann nur für den registrierten Teilnehmer ausgestellt werden.
Wundseminar

Patricia Ley ist gelernte Medizinische Fachangestellte mit den Zusatzqualifikationen Leitende MFA, ambulantes Operieren, Hygienebeauftragte, QM-Multiplikatorin, Fachkraft für die Medizinprodukte Aufbereitung. Seit 2016 Moderatorin für verschiedenste Themenbereiche im Gesundheitswesen. Seit 2022 bei Draco als Moderatorin.
Häufig zusammen gebucht
Webinar startet in
Details
* Wir nutzen Ihre E-Mail-Adresse, um Sie über ähnliche Waren und Dienstleistungen zu informieren (§7 Abs. 3 UWG). Sie können dem jederzeit widersprechen – für einzelne Maßnahmen oder insgesamt – per E-Mail (info@draco.de) oder über den Abmelde-Link in unserer Werbe-E-Mail. Es entstehen keine anderen Kosten als die Übermittlungskosten nach Basistarif.